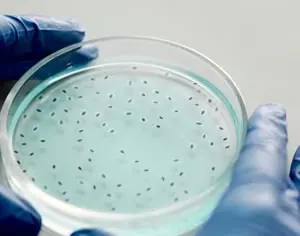
Essentielle Produkte für mikrobiologische Qualitätskontrolllabore

ARTIKEL 2: Der Einfluss der KI auf die Pharmaindustrie
7. März 2025
Dieser Artikel ist Teil einer dreiteiligen Serie über KI in der Arzneimittelentdeckung. Du kannst die gesamte Serie hier erkunden.Große Pharmaunternehmen integrieren KI in die ArzneimittelentwicklungNachfolgend sind einige Beispiele dafür aufgeführt, wie einige der größten traditionellen Pharmaunter...

ARTIKEL 1: Die Rolle der KI in der Wirkstoffforschung
7. März 2025
Dieser Artikel ist Teil einer dreiteiligen Serie über KI in der Arzneimittelentdeckung. Du kannst die gesamte Serie erkundenArtikel 1: Die Rolle der KI in der ArzneimittelentdeckungEinführungWie wird KI in der Arzneimittelentdeckung eingesetzt?Welches war das erste durch KI entdeckte Medikament?Arti...

129 Jahre seit der Entdeckung der Radioaktivität: von Becquerel bis Marie Curie und ihre Auswirkungen auf die moderne Wissenschaft
1. März 2025
Am 1. März 1896 machte der Physiker Henri Becquerel eine Entdeckung, die die Geschichte der Wissenschaft für immer verändern sollte: die Radioaktivität. Diese zufällige, aber revolutionäre Entdeckung öffnete die Türen zu einer neuen Ära in der Physik und Chemie. Kurz darauf vertieften Marie und Pie...

Mario Molina: Nobelpreisträger für Chemie und Beschützer der Ozonschicht
23. Februar 2025
Mario Molina war ein mexikanischer Chemiker, dessen Forschung unser Verständnis der Auswirkungen menschlicher Aktivitäten auf die Umwelt grundlegend veränderte. Geboren 1943 in Mexiko-Stadt, wurde Molina 1995 mit dem Nobelpreis für Chemie ausgezeichnet für seine Arbeit über die Auswirkungen von Fluo...

Von der Verbrechensaufklärung zur biochemischen Forschung
21. Februar 2025
Wusstest du, dass chemilumineszentes Licht zur Aufklärung von Verbrechen beigetragen hat?An vielen Tatorten sind entscheidende Beweise mit bloßem Auge nicht sichtbar. Doch dank der Chemilumineszenz kann die Chemie das Unsichtbare sichtbar machen. Eines der faszinierendsten Beispiele ist Luminol, ein...

Yoshinori Ohsumi: Eine revolutionäre Entdeckung zur Autophagie
9. Februar 2025
Im Jahr 2016 wurde Yoshinori Ohsumi mit dem Nobelpreis für Physiologie oder Medizin für seine bahnbrechenden Entdeckungen über die Mechanismen der Autophagie ausgezeichnet. Autophagie ist ein essenzieller biologischer Prozess, durch den Zellen beschädigte oder unnötige Komponenten recyceln. Dieser M...

Das Potenzial von Building Blocks für Innovation und Effizienz freisetzen
3. Februar 2025
Building Blocks revolutionieren die molekulare Synthese, indem sie einen effizienten, kostengünstigen und nachhaltigen Ansatz zur Herstellung komplexer Moleküle bieten. Diese modularen, vorgefertigten Komponenten vereinfachen den Syntheseprozess und ermöglichen eine schnellere Innovation in Branchen...

Chemikalien auf Lager mit sofortigem Versand
1. Februar 2025
Bei CymitQuimica wissen wir, wie wichtig es ist, keine Zeit zu verlieren, wenn ein Projekt läuft oder eine Forschung nicht warten kann. Deshalb bieten wir Ihnen eine große Auswahl an sofort versandfertigen Chemikalien auf Lager.Sparen Sie Zeit und vermeiden Sie UnterbrechungenSchneller Zugang zu den...

Digitale Plattformen zur Optimierung der Entdeckung bioaktiver Moleküle
23. Januar 2025
In den letzten Jahren hat sich die Entdeckung von bioaktiven Molekülen dank digitaler Plattformen, die Forschungs- und Entwicklungsprozesse optimieren, erheblich weiterentwickelt. Diese Tools haben die Art und Weise revolutioniert, wie Forscher Verbindungen mit therapeutischen Eigenschaften identifi...

Erwecken Sie das Vermächtnis von Har Gobind Khorana: Der Pionier, der den genetischen Code entschlüsselte!
9. Januar 2025
Im Jahr 1968 wurde Har Gobind Khorana mit dem Nobelpreis für Physiologie oder Medizin für seine Arbeit an der Interpretation des genetischen Codes ausgezeichnet, einer bahnbrechenden Entdeckung, die die molekulare Biologie revolutionierte. Durch seine Forschung gelang es Khorana, zu entschlüsseln, w...
Essentielle Produkte für mikrobiologische Qualitätskontrolllabore
7. Januar 2025
In der mikrobiologischen Qualitätskontrolle ist es entscheidend, zuverlässige Reagenzien und Materialien zu beschaffen, um präzise und konsistente Ergebnisse sicherzustellen. Bei CymitQuimica verstehen wir, wie herausfordernd es sein kann, wichtige Artikel für Routineprüfungen zu finden. Deshalb fre...

Welt-AIDS-Tag: Die globale Herausforderung verstehen und bewältigen
1. Dezember 2024
Der Welt-AIDS-Tag, der jedes Jahr am 1. Dezember begangen wird, ist ein entscheidender Moment, um Menschen weltweit im Kampf gegen HIV/AIDS zu vereinen, Unterstützung für Betroffene zu zeigen und derjenigen zu gedenken, die an dieser Krankheit gestorben sind. Trotz der Fortschritte in der Behandlung...

Albertus Magnus: Ein Vorreiter der modernen Chemie
15. November 2024
Albertus Magnus: Ein Vorreiter der modernen Chemie
Am 15. November wird das Fest des Albertus Magnus gefeiert, eines mittelalterlichen Denkers, dessen Einfluss weit über die Philosophie und Theologie hinausgeht. Obwohl er heute vor allem für seine Arbeiten in diesen Bereichen bekannt ist, war Albert...

Mole-Tag, 23. Oktober
23. Oktober 2024
Am vergangenen 23. Oktober wurde der Mole-Tag gefeiert, ein sehr wichtiges Datum für die Chemie und die Wissenschaft im Allgemeinen.Aber was ist ein Mol? Für diejenigen, die mit dem Begriff nicht vertraut sind: Ein Mol ist eine Maßeinheit, die in der Chemie verwendet wird, um die Menge einer Substan...

Feier der Nobelpreisträger 2024 in Wissenschaft
22. Oktober 2024
Bei CymitQuimica sind wir begeistert von wissenschaftlichen Durchbrüchen, die die Grenzen des Wissens erweitern und einen nachhaltigen Einfluss auf Forschung und Entwicklung haben. Die Gewinner des Nobelpreises 2024 in Physiologie oder Medizin, Physik und Chemie wurden für ihre bahnbrechenden Beiträ...

Neueste Fortschritte in der Peptidforschung
25. September 2024
Peptide sind Ketten von Aminosäuren, die durch Amidbindungen verbunden sind, ähnlich wie Proteine, aber mit weniger als 100 Aminosäuren. Ihre Anwendung als therapeutische Wirkstoffe bietet bemerkenswerte Vorteile aufgrund ihrer hohen Spezifität und Aktivität und verspricht eine vielversprechende Zuk...

Die Wirkstoffbibliotheken von TargetMol
18. September 2024
TargetMol, eine unserer Marken, bietet Wirkstoffbibliotheken mit über 8000 niedermolekularen Verbindungen verschiedener Typen, Strukturen und Maßstäbe an, mit dem Ziel, die Effizienz bei der Entdeckung neuer Medikamente zu verbessern. Diese Bibliotheken werden von Forschungseinrichtungen und Pharmau...

Welt-Zystische-Fibrose-Tag
8. September 2024
Jedes Jahr soll der Welt-Zystische-Fibrose-Tag das Bewusstsein für diese genetische Krankheit schärfen, die Tausende von Menschen betrifft. Bei CymitQuímica unterstützen wir Forscher, die daran arbeiten, die Lebensqualität der Patienten zu verbessern.Zystische Fibrose verstehenZystische Fibrose ist ...
Auswahl an Silikonprodukten von Gelest
6. September 2024
Gelest bietet eine breite Palette von inerten Silikonmaterialien an, mit Daten zu deren thermischen, rheologischen, elektrischen, mechanischen und optischen Eigenschaften. Diese Verbindungen sind dank ihrer ingenieurtechnischen und konstruktiven Eigenschaften für Anwendungen in der Wärmeübertragung,...

World RNA Day
1. August 2024
Am 1. August feiern wir den Welt-RNA-Tag, ein Datum, das dazu dient, das Bewusstsein für die Bedeutung dieses Moleküls in der Biologie und der modernen Medizin zu schärfen und die Menschen darüber aufzuklären.RNA, oder Ribonukleinsäure, ist ein essenzielles Molekül für das Leben und spielt eine ents...